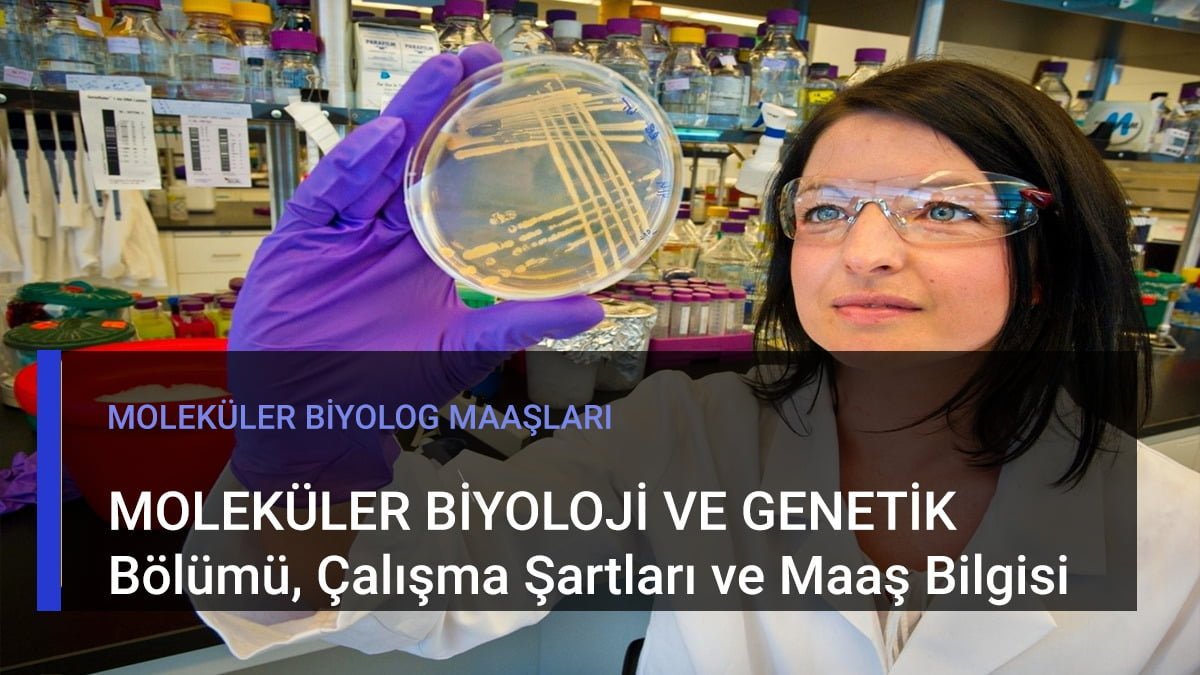

Moleküler biyoloji ve genetik bölümü, son zamanların en popüler bölümlerinden birisi. Dolayısıyla birçok insan moleküler biyolog maaşını merak ediyor.
Peki, Ocak zamlarından sonra moleküler biyolog maaşları 2025’te ne kadar oldu? Sizin için araştırdık…
Devlette Moleküler Biyolog Maaşları 2025

Moleküler biyolog maaşı, bu alana ilgi duyan kişilerin oldukça dikkatini çekiyor. Dilerseniz hep birlikte moleküler biyolog maaşları ne kadar? İnceleyelim.
Moleküler biyologlar, hücrelerin moleküler düzeyde var olan yapılarını inceleyen, aynı zamanda bu yapıların işlevlerini araştıran bilim insanıdır.
Bununla birlikte çeşitli organizmaların genetik bilgilerinin birbirini izleyen nesillere nasıl aktardığını incelerler.
Moleküler biyolog maaşları 2025 yılı için mevcut zamlara göre aşağıdaki gibidir:
Deneyim Maaş 1 Yıl Deneyimli Moleküler Biyolog Maaşı 37.500 TL – 45.000 TL 5 Yıl Deneyimli Moleküler Biyolog Maaşı 43.000 TL – 50.000 TL 10 Yıl Deneyimli Moleküler Biyolog Maaşları 48.000 TL – 65.000 TL 20+ Yıl Deneyimli Moleküler Biyolog Maaşı 54.000 TL – 70.000 TL
Moleküler Biyoloji ve Genetik Özel Sektör Maaşı Ne Kadar?
Moleküler biyoloji ve genetik özel sektör maaşı ne kadar olduğu büyük bir merak konusu! Hadi, hep birlikte bu konuya açıklık getirelim.
Moleküler biyolog maaşları, edinilen tecrübe, yaşanılan konum gibi konulara göre değişkenlik gösterir. Ayrıca çalışma ortamı da bu faktörleri tetikler.
Peki, moleküler biyoloji ve genetik özel sektör maaşı ne kadar? Hep birlikte öğrenelim!
Moleküler biyoloji ve genetik özel sektör maaşları, ortalama olarak 37.500 TL – 65.000 TL arasında değişkenlik gösterir. Bu sayı, işe dair yetkinliğiniz ve tecrübeniz sayesinde daha üst seviyelere çıkabilir.
Bu noktada birçok kişi, moleküler biyolog olarak yurt dışı imkanlarını inceliyor.
Moleküler Biyoloji ve Genetik Nedir?
Moleküler biyoloji ve genetik bölümü, geniş kapsamlı ve sürekli olarak bilimsel gelişmelerle birlikte ilerler. Bununla birlikte diğer bilim dallarıyla sürekli olarak iletişim halinde olan bir bilim dalıdır. Bir moleküler biyolog teknolojik gelişmelerden haberdar olmalıdır!
Bununla birlikte moleküler biyoloji ve genetik uzmanları, moleküllerin temel niteliklerini, yapı ve çalışmalarını inceler.
Tüm bu görevlerin sonucunda da yapılacak işe bağlı olarak değişecek mesleki deneyime ve beceriye göre moleküler biyolog maaşları da değişiklik göstermektedir.
Aynı zamanda bu moleküllerin birbirleriyle girdiği etkileşimleri, çeşitli gelişim evrelerini, işleyiş ve patolojik durumlarını göz önünde bulundurarak araştırma yapar.
Moleküler Biyoloji ve Genetik Dersleri Nelerdir?

Moleküler biyoloji ve genetik bölümü, iş olanakları açısından size geniş bir imkan sunar. Bu bölümü tercih etmek isteyen ya da aklındaki soru işaretlerini gidermek isteyen adaylar için bu bölümün ders bilgilerini araştırdık.
Moleküler biyoloji ve genetik bölümünde verilen derslerin neler olduğu sorusu araştırmaların içinde! O halde gelin, hep birlikte moleküler biyoloji ve genetik bölümünde verilen derslerin neler olduğunu inceleyelim…
Moleküler Biyoloji dersleri şu şekildedir:
- Genel Kimya
- Genel Biyoloji
- Moleküler Hücre Biyolojisi
- Hücresel ve Moleküler Fizyoloji
- Moleküler Genetik
- Veri Tabanı Yönetim Sistemleri
- Biyoinformatik
- Genomiks ve Proteomiks
- Mikrobiyoloji
- Genomik ve Genetiğin Biyoetiği
- Kök Hücre Biyolojisi
- İmmunoloj
Moleküler biyolog maaşlarıyla ilgili olarak adliye de çalışan personellerin maaşlarını da inceleyelim. Kriminal alanda hizmet veren adli biyolog maaşı ne kadar?
Adli Biyolog Maaşları Ne Kadar?

Adli biyolog uzmanları, var olan suç olayını aydınlatmaya katkısı olabilecek her türlü maddeyi inceler. Hücre, parafine gömülü doku, kan, saç, kemik, kıl, tükürük gibi birçok şeyin araştırmasından ve örneklerin incelenmesinden sorumludur.
Peki, Adli biyolog maaşları ne kadar? Gelin, hep birlikte öğrenelim!
- Adli biyologlar, aylık ortalama olarak 37.365 TL – 39.039 TL arasında maaş alır. Kıdem yılına göre değişkenlik gösterir.
Bununla beraber bu sayı, edinilen tecrübe ve çevresel faktörlere göre değişiklik gösterir. Aynı zamanda işi yapacak olan kişinin yetkinliği de işverenlerin önemli ölçüde dikkatini çeker.
Moleküler biyolog maaşları her ne kadar daha fazla gibi gözükse de adli biyologlarla ortalama olarak aynıdır. Yani kıdem ve derecesi aynı olan iki personel arasında çok fark bulunmaz.
Adli Biyolog olmak için KPSS ile atanmanız gerekir. Bağlı olacağınız yer ise Polis Kriminal Laboratuvarları, Jandarma Kriminal veya Adli Tıp Kurumu gibi devlete hizmet eden kurum ve kuruluşlardır.
Adli Biyolog olmak için genellikle üniversitelerin Biyoloji veya Moleküler Biyoloji ve Genetik lisans bölümlerinden mezun olduktan sonra yüksek lisans seviyesinde bu alanda uzmanlaşmanız beklenir.
Moleküler Biyolog Çalışma Alanları
Moleküler biyologlardan çeşitli kurum ve kuruluşlarda görev alabilmektedir.
Moleküler biyolog çalışma alanlarından bazıları şu şekildedir:
- İlaç üretimi yapan firmalar
- Gıda ve yem işletmeleri
- Okullar
- Kozmetik üretimi yapan fabrikalar
- Hijyen eğitimi veren kuruluşlar
- Gıda kontrol laboratuvarları
- Hastaneler
- Üniversiteler
- Biyokimya laboratuvarları
- Kök hücre nakil merkezleri
- Tip bebek merkezleri
- Kan hizmetleri birimleri
- Genetik hastalıklar tanı merkezi
- Araştırma Enstitüleri
Nasıl Moleküler Biyolog Olunur?
Moleküler Biyolog olmak, birçok kişinin hayali! Aynı zamanda nasıl biyolog olunur sorusunun cevabını merak eden yüzlerce kişi var. Dilerseniz bu merak edilen konuya hep birlikte açıklık getirelim.
Moleküler Biyolog olarak meslek hayatına atılmanız için öncelikli olarak Yükseköğretim Kurumu’nun hazırlamış olduğu TYT (Temel Yeterlilik Sınavı) ve AYT (Alan Yeterlilik Sınavı)‘den belirlenen taban puanının alınması gerekiyor.
Akabinde puanınıza göre bölüm tercihlerinizi yapmanız gerekiyor. Bu süreçte sizlere yardımcı olabilmek için nitelikli üniversiteler adına; moleküler biyoloji ve genetik bölümü taban puanları tablosu hazırladık.
Bölüm tercihlerinizin sonrasında herhangi bir moleküler biyoloji ve genetik bölümü bitirdikten sonra kariyer basamaklarına moleküler biyolog olarak çıkabilirsiniz! Bu süreçte kendinizi geliştirmeniz, işverenlerin dikkatini çekecektir.
Perfüzyon Teknikleri bölümü hakkında ne biliyorsunuz? Biyoloji alanına ilgiliyseniz hemen “Perfüzyonist Maaşları” yazımıza göz atın’!
Moleküler Biyoloji ve Genetik Bölümü Taban Puanları Nelerdir?

Moleküler biyoloji ve genetik alanına merak duyan kişiler, moleküler biyoloji ve genetik bölümü taban puanları nelerdir sorusunun cevabını da merak ediyor. O zaman gelin, hep birlikte bu soruya açıklık getirelim!
Moleküler biyoloji ve genetik bölümü taban puanları aşağıdaki tabloda verilmiştir:
| Boğaziçi Üniversitesi | 449 Taban Puan |
| Orta Doğu Teknik Üniversitesi | 433 Taban Puan |
| İstanbul Teknik Üniversitesi | 420 Taban Puan |
| İzmir Yüksek Teknoloji Enstitüsü | 395 Taban Puan |
| Yıldız Teknik Üniversitesi | 380 Taban Puan |
| İstanbul Üniversitesi | 372 Taban Puan |
| Gebze Teknik Üniversitesi | 370 Taban Puan |
| Bursa Uludağ Üniversitesi | 314 Taban Puan |
Moleküler Biyoloji ve Genetik Bölümü Zor Mu?
Moleküler biyoloji ve genetik bölümü zor mu sorusu, bu alana yönelik meraklıların cevabını aradığı bir konu. Dilerseniz hep birlikte bu soruya açıklık getirelim.
Moleküler biyoloji ve genetik bölümü, fen derslerini esas alır. Dolayısıyla sayısal zekası gelişmiş olan bireyler, bu bölümü rahatlıkla bitirebilir.
Fakat sayısal zekanız gelişmemiş de olsa planlı ve programlı bir çalışmayla siz de moleküler biyoloji ve genetik bölümündeki dersleri kolaylıkla geçebilirsiniz! Bu aşamada kendinize olan güvenin tam olması yeterlidir.
Acil Tıp Teknisyenlerinin çalışma şartları hakkında tüm merak ettikleriniz “ATT Maaşları” yazımızda! Hemen tıklayın!
Moleküler biyolog maaşları 2025 bilgilerini inceledik. Siz bu konu hakkında ne düşünüyorsunuz? Düşüncelerinizi yorumlar aracılığıyla bizimle paylaşabilirsiniz!
Benzer Yazılar
Daha Fazla Makale
















